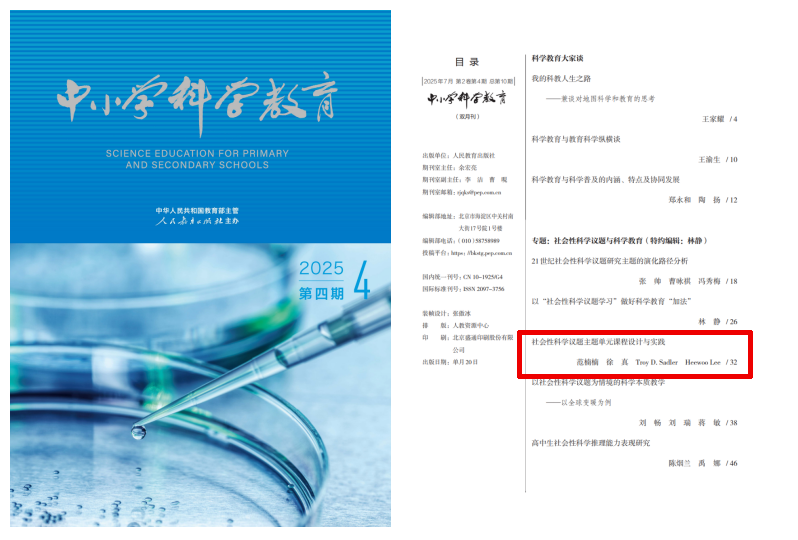
1.png

北京师范大学社会性科学议题学习项目研究成果
文章标题:社会性科学议题主题单元课程设计与实践
作者:范楠楠、徐真、Troy D.Sadler、Heewoo Lee
作者单位:美国北卡罗来纳大学教堂山分校教育学院
本文来源:《中小学科学教育》2023年12期
摘要:为了促进科学知识的学以致用,以社会性科学议题为主题的课程设计受到国内外科学教育研究界的广泛关注。社会性科学议题与建模的单元课程设计框架包含探索潜在科学现象、开展科学建模、考虑议题的系统动态性、应用信息媒介素养、权衡多方视角和阐明个人立场六个模块。根据实践经验,社会性科学议题主题单元课程应在覆盖各模块的同时兼顾课程连贯性,重视师生在课程实施中的角色分工,关注形成性评价与反馈机制。
基金:
为了促进科学知识的学以致用,以社会性科学议题(socio-scientific issues,SSI) 为主题的课程设计受到国内外科学教育研究界的广泛关注。社会性科学议题是指那些与科学和技术相关的社会性议题,往往具有开放式、极富争议性、存在多种解决方案等特点[1],与生态环境、资源使用、食品安全等主题相关。中国关于SSI课程设计及教学的研究多侧重论证能力培养[2-4]、科学本质理解[5-6]、科学知识和跨学科大概念的学习和应用[7-8]等方面,且多以单个课例形式呈现。鲜有研究基于SSI课程设计的理论框架展开单元课程设计。由于缺乏适当的课程开发案例、资源和工具,多数一线科学教师始终不知如何将SSI融入自己的课堂之中。[9]因此,本文着力探讨SSI课程理论框架的基本要素,追溯该框架所彰显的科学教育目标。在此基础上,从理论回归实践,围绕“塑料污染”这一议题呈现SSI课程实例。最后,从课程设计、实施与评价的视角,为一线科学教师的SSI教学提供一些新思路。
一、 SSI课程理论框架的基本要素
罗伯茨(Roberts)对科学素养进行了两种视角的分类:“视角一”强调从科学家视角理解科学知识,从科学知识的产生过程来规划教学顺序,并尽可能多地掌握科学概念和科学公式;“视角二”则强调从学习者的视角,理解科学知识并将其运用到日常生活情境中,结合复杂的情境解决真实的生活问题。[10]“视角二”下的科学素养强调的是科学在社会中扮演的角色,将科学与日常生产生活中的真实情境联系起来,兼顾与科学相互作用的政治、经济、伦理等社会性因素。这一视角转向给科学教育的课程与教学设计提出了巨大挑战。笔者所在团队在与美国一线科学教师的多次合作中,开创并发展了社会性科学议题与建模(socio-scientific issue and model based learning,SIMBL)的单元课程设计框架(见图 1 )。[11]该框架围绕选定的议题,通过六个关键模块的灵活组合,为教师设计和开发以SSI为核心的单元课程提供了系统性的理论支撑。

SIMBL框架以与学生日常生活相关的SSI为情境,通过设计相应的教学活动,让学生探索潜在科学现象,开展科学建模,考虑议题的系统动态性,应用并提升信息媒介素养,在权衡多方立场和观点的同时阐明和论证自己的观点,最终解决相应的问题。六个模块之间没有既定顺序,但鼓励教师设计单元课程时囊括六个模块。教师可在保证单元课程系统性和连续性的基础上,自主选择任意模块展开课程内容。下面对这六个模块做简要说明。
探索潜在科学现象意味着SSI单元课程应始于一些有趣且与学生日常生活紧密相关的科学问题或现象,以便激起学生的求知欲,并在后续的课程内容中反复回到最初的科学现象,寻找合理的解决路径。开展科学建模作为一种辅助学生进行科学推理的认知活动,让学生通过建构、评价、修改模型,更加深刻地理解复杂的科学现象。考虑议题的系统动态性意在帮助学生理解科学现象背后涉及的政治、经济、伦理等多种因素,以便从多个角度思考SSI的系统复杂性。应用信息媒介素养侧重让学生形成获取、评估、鉴别和使用多渠道信息的能力,成为高水平的现代信息媒介的“消费者”。权衡多方视角试图让学生站在别人的立场思考问题,理解不同观点背后的利益诉求。阐明个人立场意在培养学生作出决策并论证个人观点的能力,使学生依据所学提供自己的解决策略,并在此基础上辩护所提策略的优势。
SIMBL框架从单元课程设计的角度为提升学生科学素养提供了切实具体的实践步骤,从主题的选择、多种科学实践的考量和落实,到观点论证和问题解决能力的培养,始终将学生的科学学习置于“类生活”的情境之中,服务于学生“看得见”的需要。课程设计不再强调零散的科学概念和单调重复的科学实验,而是将学生置于真实的科学问题情境之中,推动他们尝试解决问题。因为个体的能力是镶嵌在情境里的,不存在脱离情境的能力。[12-14]
二、SIMBL单元课程设计框架的应用实例
以下是笔者围绕“塑料污染”主题展开的SSI单元课程设计案例。考虑到单元课程内容的完整性和系统性,本文展示了该单元课程的全部内容,但并非每节课都须与SIMBL框架的六个模块一一对应。模块之间没有先后顺序,教师可根据SSI的潜在属性或单元课程内容的连贯性自主决定各模块的位置,只要整个单元覆盖了六个关键模块即可。
SSI 单元课程设计通常始于一个复杂的、与学生日常生活密切相连且亟待解决的争议话题。学生通过参与科学建模、进行争论、思考社会及科学要素、应用媒介信息等进行科学实践,同时学习科学概念,借助单元评价任务对整个单元的学习过程进行整合、反思。图2简要呈现了基于SIMBL框架的单元课程内容。

(一)探索潜在科学现象:塑料污染与“太平洋垃圾带”
本单元主要围绕“塑料污染”主题展开,以八年级学生为授课对象。由于“塑料污染”主题本身十分宽泛,有必要从一个与该主题密切相关且对学生有直观冲击的现象出发。垃圾倾倒和流入形成的“太平洋垃圾带”(GreatPacific garbage patch)一直困扰着沿海国家和地区。其中,塑料垃圾是“太平洋垃圾带”的主要污染物。教师先向学生呈现海洋塑料污染的现状,如像水母一样的透明塑料袋、被渔网缠住的乌龟、误食塑料致死的海鸟等,激起学生的好奇心和求知欲,推动他们进一步探究“太平洋垃圾带”是如何形成的。接着,教师为学生提供“在线塑料垃圾追踪模拟器”
学生输入任意一个地理位置,模拟器便会模拟出该地区塑料垃圾随着附近的河流涌向不同海洋垃圾带的可能路径,并预测其流入海洋的可能性。与此同时,教师可以向学生提供当地的河流水系分布图,帮助学生进一步理解河流走向与海洋垃圾形成的关系,认识到“太平洋垃圾带”与他们日常生活的关联。
为了将海洋塑料污染延伸到更广泛的塑料污染,教师可结合学生所在地区的时事新闻,如某河流中发现大量的微塑料(尺度小于5 mm 的塑料颗粒),政府向餐馆、超市、药店使用的塑料袋征税,某垃圾填埋场即将达到饱和等,进一步向学生传达塑料污染无处不在的“危险”信息。“太平洋垃圾带”作为一个贯穿整个单元的学习情境,会在后续被反复提及。它不只是单元开篇的“锚”,还能支撑后续内容的学习。
(二)开展科学建模:塑料污染是如何影响海洋生态环境的
科学模型作为一种辅助学生进行科学推理的认知工具,能够将思考过程具象化。让学生参与建构、评价、修改模型的过程,有助于他们理解复杂的科学现象。从广义上看,科学模型包括多种形式,如数学等式、图表、实物模型甚至是计算机模拟系统等。为了让学生进一步理解海洋塑料污染是如何影响海洋生态环境的,教师先让学生复习食物链、食物网等相关科学概念,并在此基础上引导学生画出海洋生物之间相互影响的机制模型,通过列出不同等级的生产者、消费者、分解者,让学生比较、修改自己所绘制的食物网关系图。教师可以引导学生从不同角度思考塑料对海洋的影响,如大体积的塑料产品漂浮在海洋表面可能会阻碍光线入海,影响浮游水藻的生长;大型塑料经过多次分解,变成人眼不可见的微塑料,被海洋生物误食后可能会导致不良后果。无论将学生的思考引向何方,都应让建构、评价、修改模型成为理解和解决问题的工具,而非学习的目的。在学生开展科学建模之前,应帮助他们尽可能多地理解海洋生态系统内部的相互关系。
(三)考虑议题的系统动态性:如何选择垃圾焚烧发电厂的地理位置
如前所述,该模块意在帮助学生从多个角度思考SSI的系统复杂性。在本单元,教师主要引导学生同时思考与塑料污染相关的科学性和社会性因素,聚焦塑料垃圾的管理与垃圾填埋或焚烧场所的选址问题。填埋和焚烧作为塑料产品管理的重要手段,尽管存在各种争议,却一直是塑料垃圾处理的主要方式。2019年,某综艺节目中提到“某地三年产生的垃圾足以填满西湖”,引发公众对垃圾填埋处理方式的思考,垃圾焚烧发电厂逐步得到青睐。但发电厂面临选址上的“邻避效应”,即“为什么建在我这里而不建在他那里”。在选址问题上,公众争议较大的通常是“如何解决垃圾焚烧厂的异味”和“对周围生态环境的影响”,有的人甚至会关注周边房价的跌幅。因此,教师可以介绍相关争议事件的起因、发展以及结果,帮助学生理解垃圾焚烧发电厂的选址因素和当地政府的解决策略。随后,教师可以给学生提供一个涉及经济、环境等因素的新问题情境,让学生思考权衡如何选择焚烧厂的地理位置,并给出相应的论据。
(四)应用信息媒介素养:微塑料是如何影响人类健康的
从信息媒介素养的角度来看,学生在筛选信息的过程中,应重点关注以下四个方面:新闻媒体报道所传达的内容、作者及其写作意图、预设的目标读者、在信息生产或传播中可能存在的潜在偏见(作者的专业背景或相关经验)。近年来,新闻媒体关于在人体中发现微塑料的报道层出不穷,但对微塑料到底对人体有没有伤害这个关键问题没有给出统一确切的结论。教师可让学生围绕“微塑料与人类身体健康”展开网络搜索,并在此过程中重点关注上述四个方面。学生搜索得到的信息可能包括科普类短视频、期刊文章、新闻报道、报纸评论等。教师让学生对搜索得到的信息进行整合与分类,并做进一步的分析、鉴别和应用。
(五)权衡多方视角:是否应该禁止塑料垃圾的进出口
SSI的复杂性为学生理解利益相关者的多种观点创造了可能。在本单元中,教师以“塑料垃圾进出口”为焦点,让学生阅读相关的统计数据和新闻报道,理解贫富程度不同的国家在塑料垃圾进出口中的角色定位,梳理相应的论点及论据。这些阅读材料会引导学生从不同国家的视角出发,思考进出口塑料垃圾的优缺点。教师也可以进一步介绍进口塑料垃圾的后续处理方式及其可能带来的地域性及全球性影响。在学生理解多方观点的基础上,教师再邀请他们选择自己的立场,搜集相应证据,展开相互论证。
(六)阐明个人立场:如何减少塑料污染
通过整个单元的学习,学生能够依据所学提供自己的问题解决策略,并在此基础上论证所提策略的优势。本单元的评价项目是让学生从塑料产品的生产原料、塑料垃圾的管理方式以及塑料的替代产品等角度中选择一种提出减少塑料污染的方案。学生需要就自己的方案进行文本、草图呈现或现场展示,并接受同学和教师的评价反馈,也可以邀请相关领域的专家帮助自己完善方案。方案设计既为学生创造了学以致用的平台,又能使学生得到相应的反馈。
三、SSI单元课程设计实施的注意事项
(一)在覆盖各模块的同时兼顾课程连贯性
尽管我们倡导SSI单元设计要涵盖SIMBL框架的六个模块,但并未指定六个模块的先后顺序和相应的课时,也没有强制性地要求每个教学活动都需要体现这六个模块。确切地说,在设计SSI单元课程时,需要根据学生对知识的理解顺序设计课程故事线,并在逻辑通顺的故事线中穿插六个模块的活动内容。SSI单元课程旨在为学生营造一个相对完整的生活化学习体验,让学生能够自主建立起课堂所学与生活所用之间的关系。所以,课程设计需要预设学生可能遇到的问题或困境,引导学生深入理解议题背后的科学知识和社会争议。主题的选择作为整个单元的起点和重点,需要兼顾多方面的因素:一是应具有极强的争议性且没有准确统一的答案,不同的利益相关者可以发表不同的观点;二是应承载相应的科学知识,能够让学生在探究和解决问题的过程中加以应用;三是应与学生的学习和日常生活密切相关,能够激起学生对主题深入探究的兴趣。主题的选择为SSI单元课程的连贯性设计奠定了基础。教师在进行单元课程设计之前,可以组织学生就指定的主题提出问题,并将这些问题加以汇总和整合,形成一个完整的问题链,在此基础上设计整个单元的故事线。
(二)重视师生在课程实施中的角色分工
在SSI单元课程实施的过程中,教师需时刻找准自己的角色定位。不同于传统的教师主导的课堂,教师在SSI单元课程中需要扮演引导者、启发者和管理者的角色,避免发表论断性评价,鼓励学生展开有方向性的探究。通常而言,学生将教师当作课堂的唯一权威,教师的观点或评论会被学生认为是“标准答案”,从而限制学生自主观点的形成与表达。SSI的争议性本质要求教师允许课堂上各种“不确定性”的存在,也允许争论的发生。教师甚至可以提供各种不统一的科学报告或时事新闻来弱化自身的权威性,鼓励学生展开合作探究。此外,教师也需要承认学生在学习中的主体性,激发学生学习的主动性。这一目标的实现除了需要选择合适的主题,还需要教师的专业课程设计和有意识引导。例如,让学生调查并选择垃圾填埋场的地理位置,就是鼓励学生在思考议题动态性的基础上,权衡多方利益相关者的需要,最终形成相对合适的方案。学习主动性的激发需要与问题解决的动力建立联系,确定学生感兴趣的探究问题需要教师和学生的共同合作。
(三)关注形成性评价与反馈机制
从某种程度上说,SIMBL框架的六个模块像是SSI单元课程在认知层面上的跨情境、可迁移的学习目标。但每个学习目标的实现既需要深度学习的过程,也须配备相应的形成性反馈与评价。例如,学生先通过回顾陆地生物之间的食物链,了解具体的模型形式,以此为基础,进一步绘制塑料与海洋生态系统之间的相互作用图。教师适当的反馈和学生及时的修正促进了对建模的理解和进一步应用。模型作为促进学生认知学习的工具,充分记录了学生对所学知识不准确的理解以及通过对模型的改进而达到的学习效果。此外,SSI单元课程的评价也指向不同模块的学习目标,学生可以自主选择感兴趣的方向,进一步展开详细探究。
随着现代科学技术的迅猛发展,整个社会对于科学人才的要求日益严格。《中国学生发展核心素养》在科学精神中提到理性思维、批判质疑、勇于探究等要素,强调重视问题意识,借助科学的方法研究科学问题,独立思考和解决日常生活问题。[15]在 SSI 单元课程的设计中,需要有意识地关注日常争议问题的科学性和社会性,因为议题的多面性呈现出科学在人们日常生活中的真实状态。
参考文献
[1] SADLER T D, ZEIDLER D L. Patterns of informal reasoning in the context of socioscientific decision making[J]. Journal of Research in Science Teaching, 2005(1): 112-138.
[2] 李继良, 方艳. 图尔敏论证模型在“社会性科学议题”教学中的应用: 以“是否建设一座硫酸厂”为例[J]. 化学教学, 2019(5): 65-68.
[3] 白梅, 潘苏东. 物理中的SSI专题讨论式教学: 以“能源与可持续发展”的教学为例[J]. 物理教学, 2019(5): 43-45.
[4] 黄晰慧, 李秋石. 论证教学在社会性科学议题教学中的应用: 以“疫苗”为例[J]. 中学生物教学, 2022(15): 14-15.
[5] 王铭志. 高中生物SSI教学研究: 以“克隆技术”为例[J]. 中学生物教学, 2017(17): 16-18.
[6] 季薛庆, 季庆燕. 社会性科学议题情境中科学本质教学: 以转基因作物为例[J]. 全球教育展望, 2013(2): 124-128.
[7] 王福成. 在社会性科学议题中构建高效课堂: 以“电解法制备高铁酸钠”为例[J]. 中学化学教学参考, 2015(21): 50-52.
[8] 谭永平. 社会性科学议题促进跨学科学习[J]. 中小学科学教育, 2024(2): 18-21.
[9] 万东升, 魏冰. 以当代科学实践为情境的科学教学模式初探[J]. 课程·教材·教法, 2016(12): 85-90.
[10] ROBERTS D A. Scientific literacy/science literacy[M]//ABELL S K, LEDERMAN N G. Handbook of research on science education. Mahwah: Lawrence Erlbaum Associates, 2007: 729-780.
[11] SADLER T D, MURAKAMI C D. Socio-scientific issues based teaching and learning: hydrofracturing as an illustrative context of a framework for implementation and research[J]. Revista Brasileira de Pesquisa em Educação em Ciências, 2014(2): 331-342.
[12] BROWN J S, COLLINS A, DUGUID P. Situated cognition and the culture of learning[J]. Educational Researcher, 1989(1): 32-42.
[13] LAVE J, WENGER E. Situated learning: legitimate peripheral participation[M]. Cambridge: Cambridge University Press, 1991: 49-52.
[14] LAVE J. Cognition in practice: mind, mathematics, and culture in everyday life[M]. Cambridge: Cambridge University Press, 1988: 69-70.
[15] 核心素养研究课题组. 中国学生发展核心素养[J]. 中国教育学刊, 2016(10): 1-3.